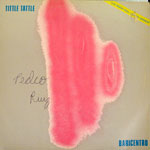

|
|
 |
20120929-02 |
 |
20120929-05 |

 |
20120929-07 |
 |
20120929-10 |

 |
20120929-11 |
 |
20120929-15 |

 |
20120929-18 |

 |
20120929-21 |

|
20120929-31 |
 |
20120929-32 |
 |
20120929-33 |
 |
20120929-35 |

 |
20120929-37 |
 |
20120929-39 |
 |
20120929-40 |

 |
20120929-41 |
 |
20120929-42 |
 |
20120929-45 |
 |
20120929-47 |
|
Copyright
c 2005 by E.A.D Record All Rights Reserved. |

































